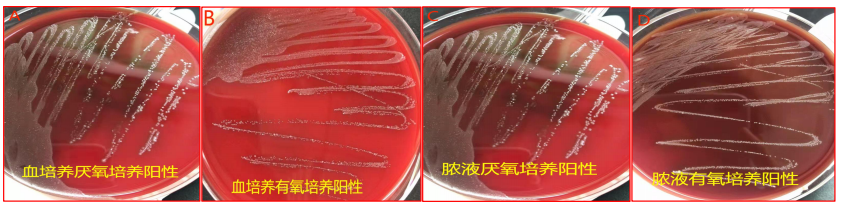

查看更多
密码过期或已经不安全,请修改密码
修改密码
壹生身份认证协议书
同意
拒绝
同意
拒绝
同意
不同意并跳过
笔者近日收治1例细菌性肝脓肿患者,此病发病率低,多见于糖尿病、免疫抑制、晚期肿瘤等患者。本例为中年女性,既往体健,无特殊病史。但因患者“心大”疏忽致病情迅速进展,就诊时肝脓肿已达10cm以上,脓腔临近肝脏表面,如未及时治疗,脓肿破溃将发生严重后果。
病史摘要:
患者“心大”无视病情
患者女,57岁,因“右上腹闷胀伴乏力、畏冷10天”入院。
2021年11月21日无明显诱因出现右上腹闷胀,伴乏力、畏冷寒战,未测体温,肩背部僵硬活动受限,无咳嗽、咳痰,无恶心、呕吐,无腹痛、腹泻、黑便,无尿频尿急、尿痛,服用桑叶泡水后肩背不适好转,但仍感腹胀、畏冷。
11月23日就诊于社区医院,行腹部彩超示肝内8.2cm×6.2cm低回声结节,予“消炎利胆片、新癀片”治疗后症状无明显好转。
11月29日自觉症状加重,至医院就诊,上腹部CT示肝右叶9.3cm×7.8cm巨大囊样占位;血常规示:白细胞14×109/L↑、中性粒细胞80.0%↑。
为进一步诊治,12月1日就诊我院,门诊以“肝占位性病变”收入我科。
入院检查:
肝脏巨大囊样占位
查体:体温36.7℃、脉搏107次/分、血压131/78mmHg,神清,精神差,双肺呼吸音粗,双下肺可闻及湿性啰音;心律齐,各瓣膜未闻及病理性杂音;腹平,右上腹肌稍紧张,轻压痛,无反跳痛,未触及包块,肝脾肋下未触及,Murphy征及移动性浊音阴性,肠鸣音正常。
辅助检查:尿常规隐血1+,大便OB弱阳性,血常规、炎症指标及生化检查见表1;肿瘤指标、肝炎病毒学指标、凝血指标正常。
表1. 血常规、CRP、PCT、IL-6及生化检验

CT:右侧胸腔大量积液及膈肌右侧上抬继发右肺膨胀不全、左侧胸腔少量积液、心包少量积液、肝内巨大团块影(图1)。

图1. 肺部及腹部CT
MRI:肝右叶上段可见多房样异常信号影,大小约10.3cm×8.8cm,T2WI呈高低混杂信号,T1WI呈低信号,弥散受限,增强扫描呈环形及分隔样强化(图2)。

图2. 肝脏MRI 平扫+增强
初步诊断:1.肝脓肿,感染原因待查;2.贫血原因待查。
诊治经过:
肝穿引流疗效显著
入院后患者发热,体温最高达39.5℃,多次送血培养,予莫西沙星注射液(0.4g ivgtt qd)联合甲硝唑注射液(0.5g ivgtt bid)抗感染治疗。胸腔穿刺置管抽出积液750ml,呈淡黄色(图3A),胸腔积液常规+生化提示渗出液(表2),胸腔积液培养阴性。
表2. 胸腔积液常规及生化检测


图3. 胸腔积液及肝穿刺引流液(图B为60ml注射器)
磁共振示脓肿大多液化,遂超声引导下肝脓肿穿刺置单猪尾引流管(8Fr)。脓液量粗略估计(脓腔减缩后组织液渗入脓腔致实际引流量增加):假定脓腔近似球形,半径R≈5cm,脓腔体积=4πR³/3≈523cm³=523ml。抽出脓液呈棕灰色(图3B),量约190ml,适量送培养。用甲硝唑注射液约170ml反复冲洗,再留置30ml后暂夹闭引流管,每日记录胸腔积液及肝脓肿引流量(表3)。
表3. 胸腔及肝脏引流量

血生化检查提示转氨酶增高、低蛋白血症,予保肝、输人血白蛋白等治疗。12月5日患者体温恢复正常(图4A)。治疗2周后复查CT:右侧胸腔引流管置入,双侧胸腔见少量积液;肝脓肿引流管置入,右肝内约5.9cm×5.1cm低密度区,见小气泡,边界模糊(图4B-E)。


图4. 治疗后体温(部分)变化及CT复查
治疗期间监测血常规、炎症及生化指标。白细胞、中性粒细胞及白介素(IL)-6、PCT逐渐降至正常(表4),影像学显示脓肿缩小。
表4. 血常规、CRP、PCT、IL-6及生化指标复查

病情好转,
细菌培养最终锁定元凶
治疗后,患者症状明显好转,体温恢复正常。那么究竟是什么原因导致的肝脓肿?
治疗期间送血培养及脓液培养均见细菌生长,分纯后在常氧及厌氧环境中均长成菌落,提示该细菌具有在有氧、厌氧两种环境下生存的特性(图5A-D)。
图5. 血及脓液培养
血培养及脓液培养阳性菌落Gram染色试验提示该细菌为革兰阳性菌,且为同一菌属:中间链球菌(图6A)。镜检发现与Tran等报道脑脓肿镜检中间链球菌形态相似(图6B)。

图6. 培养镜检与文献报道镜检比较
最终确定本例肝脓肿的元凶是中间链球菌。中间链球菌为人体正常菌群,定植于口鼻咽、呼吸道、胃肠道和泌尿生殖道等,当机体抵抗力下降等时便可成条件致病菌,导致脏器脓肿。
药敏试验:
让治疗更加精准
中间链球菌对头孢吡肟、头孢曲松、头孢噻肟、氯霉素、左氧氟沙星、四环素、万古霉素、利奈唑胺、红霉素均敏感(K-B法),如图7所示。考虑到患者之前使用莫西沙星联合甲硝唑抗感染1周,结合药敏结果及我院现有抗生素,选用左氧氟沙星注射液(0.5g ivgtt bid)继续抗感染治疗。与此同时,密切监测更换抗生素后体温变化及临床表现。

图7. 血及脓液培养+药敏
治疗第7天复查胸腔彩超见少量积液,胸腔引流约100ml,肝引流约15ml,如图8。连续胸腔引流液量少,且彩超未见明显积液,遂拔除胸腔引流管。考虑肝脓肿完全液化、机化时间长,故暂不拔除肝引流管,嘱患者带药(盐酸莫西沙星片 0.4g qd)出院,交代门诊随诊及注意事项。

图8. 胸腔引流及肝脓肿引流液
患者出院后密切随访,无腹部不适、畏寒发热等不适。治疗第23天后肝脓肿大小3.50cm×4.47cm,血常规、炎症指标及生化未见异常(表5);第35天后肝脓肿大小3.84cm×2.90cm,第41天后肝脓肿大小3.89cm×3.87cm,脓腔逐渐缩小,如图9。口服莫西沙星2周后更换为左氧氟沙星片(0.5g qd),继续观察无引流液及任何不适。
表5. 出院后随访(血常规+CRP/IL-6/PCT+生化)


图9. 出院后肝脓肿彩超随访
顺利拔管:
医患倍感轻松
患者身上带着引流管须时刻警惕引流管牵拉脱出,不能右侧卧,生活不便。拔管前肝CT检查见病灶明显缩小(图10A-B)。谨慎起见将引流管向外拔出约2cm观察引流液是否增多。观察1天后引流管见少量淡黄清亮液体(图10C)。遂拔除引流管,猪尾巴引流管头端部分侧孔见“果冻样”坏死组织堵塞(图10D-E)。拔管后患者无明显不适,嘱患者口服保肝药。


图10. 复查肝CT及拔除后引流管
患者拔管后立感轻松,满脸喜悦。但笔者依然紧绷,因为不知道拔管后患者会有什么不适。嘱如有不适随时联系。1天、2天、3天……越来越放心了。微信随访患者无明显不适。拔管后1周复查肝彩超居然脓肿消失了,笔者顿时成就感爆棚!心底激动不已。整整50天终于治好了肖女士的肝脓肿,这段时间基本每天心里都觉得有件事没做完,看到这张彩超报告(图11)心里才踏实。

图11. 拔管后1周复查肝彩超
作者:厦门大学附属成功医院消化内科 朱小三 副主任医师
来源:消化界
查看更多